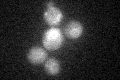
YGL186C
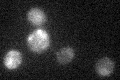
YGL186C

View description
Plasma membrane pyridoxine (vitamin B6) transporter; member of the purine-cytosine permease subfamily within the major facilitator superfamily; proton symporter with similarity to Fcy21p, Fcy2p, and Fcy22p
Localization:
Intensity:
Fold change:
Significance:
-
C’ GFP library in SD

ER20.58 -
N' NOP1pr-GFP in SD

vacuole37.578 -
N' TEF2pr-mCherry in SD

cell periphery,vacuole74.7639 -
N' NATIVEpr-GFP in SD

ER,vacuole26.9406 -
N' TEF2pr-VC and Cyto-VN in SD

below threshold23.2808 -
C’ GFP library in SD+DTT

ER14.280.69Yes -
C’ GFP library in SD+H2O2
ER17.60.85No -
C’ GFP library in Starvation Media
ER21.651.05No -
C’ GFP library on the background of Pup2-DaMP

ER -
C’ GFP library on the background of CCT mutant

ER16.21690.787578No
